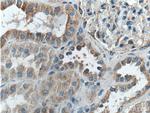
TSFM Antibody in Immunohistochemistry (Paraffin) (IHC (P))

Search
Proteintech
TSFM Polyclonal Antibody
{{$productOrderCtrl.translations['antibody.pdp.commerceCard.promotion.promotions']}}
{{$productOrderCtrl.translations['antibody.pdp.commerceCard.promotion.viewpromo']}}
{{$productOrderCtrl.translations['antibody.pdp.commerceCard.promotion.promocode']}}: {{promo.promoCode}} {{promo.promoTitle}} {{promo.promoDescription}}. {{$productOrderCtrl.translations['antibody.pdp.commerceCard.promotion.learnmore']}}
产品信息
11701-1-AP
种属反应
宿主/亚型
分类
类型
抗原
偶联物
形式
浓度
规格
纯化类型
保存液
内含物
保存条件
运输条件
产品详细信息
Immunogen sequence: MSLLRSLRV FLVARTGSYP AGSLLRQSPQ PRHTFYAGPR LSASASSKEL LMKLRRKTGY SFVNCKKALE TCGGDLKQAE IWLHKEAQKE GWSKAAKLQG RKTKEGLIGL LQEGNTTVLV EVNCETDFVS RNLKFQLLVQ QVALGTMMHC QTLKDQPSAY SKVQWLTPVN LALWEAEAGG SLEGFLNSSE LSGLPAGPDR EGSLKDQLAL AIGKLGENMI LKRAAWVKVP SGFYVGSYVH GAMQSPSLHK LVLGKYGALV ICETSEQKTN LEDVGRRLGQ HVVGMAPLSV GSLDDEPGGE AETKMLSQPY LLDPSITLGQ YVQPQGVSVV DFVRFECGEG EEAAETE (1-346 aa encoded by BC022862)
靶标信息
Synthesis of the 13 mitochondrial-encoded proteins occurs on a dedicated mitochondrial translation apparatus similar to that found in prokaryotes and requires, in addition to the tRNAs and rRNAs encoded in mtDNA, the concerted action of several translation factors and a large number of mitochondrial ribosomal proteins, all of which are encoded by nuclear genes. The TSFM gene encodes a mitochondrial translation elongation factor (Smeitink et al., 2006 ).
仅用于科研。不用于诊断过程。未经明确授权不得转售。
篇参考文献 (0)
生物信息学
蛋白别名: EF-Ts; Elongation factor Ts, mitochondrial; mitochondrial elongation factor Ts; unnamed protein product
基因别名: EFTS; EFTSMT; TSFM
UniProt ID: (Human) P43897
Entrez Gene ID: (Human) 10102